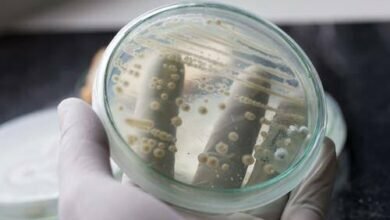
الفطريات المهبلية معدية للزوج

كثرة المشاكل الزوجية بدون سبب
كثرة المشاكل الزوجية بدون سبب: تعاني الكثير من الأزواج من مشاكل زوجية تظهر بشكل مفاجئ ودون وجود سبب واضح. يشعرون بالإحباط والارتباك لعدم فهم أسباب هذه المشاكل الغامضة. في هذه المقالة، سنتحدث عن كثرة المشاكل الزوجية بدون سبب وأهميتها.
تعريف لكثرة المشاكل الزوجية بدون سبب
تُعرف كثرة المشاكل الزوجية بدون سبب بأنها تلك المشاكل التي تحدث بين الزوجين دون وجود أسباب قوية أو مبررات واضحة. في بعض الأحيان، يُصعب على الأزواج تحديد سبب محدد لهذه المشاكل، مما يزيد من التوتر والصعوبات في حلها.
تزداد مشكلة كثرة المشاكل الزوجية بدون سبب تعقيدًا عندما يكون الثنائي غير قادر على التواصل بشكل فعال وفهم بعضهما البعض. وقد تؤدي هذه المشكلة إلى تدهور العلاقة الزوجية وتأثيرها على حياة الزوجين بشكل عام.
من أهم المسببات المحتملة لكثرة هذه المشاكل هي عدم التوافق في القيم والاحترام المتبادل بين الزوجين، والتوترات اليومية التي تنشأ من جدول أعمال مزدحم أو ضغوطات خارجية. قد يكون هناك أيضًا عوامل نفسية أو نفسية اجتماعية تؤدي إلى تصاعد المشاكل بدون سبب واضح.
في المقال التالي، سنستكشف بعض الإجراءات التي يمكن اتخاذها للتعامل مع كثرة المشاكل الزوجية بدون سبب وبناء علاقة زوجية صحية ومستدامة.
العوامل النفسية
أسباب نفسية قد تؤدي إلى كثرة المشاكل الزوجية بدون سبب
تواجه العديد من الأزواج مشاكل زوجية دون سبب واضح، حيث يبدو أن هناك توتر وصراعات تنشأ دون سبب ملموس. قد يرجع ذلك إلى بعض العوامل النفسية التي قد تؤثر على العلاقة الزوجية. فيما يلي بعض الأسباب النفسية التي يمكن أن تؤدي إلى كثرة المشاكل الزوجية بدون سبب:
- قصور التواصل: قد يؤدي عدم التواصل الجيد بين الزوجين إلى زيادة التوتر والخلافات. عدم القدرة على التعبير عن المشاعر والاحتياجات بشكل صحيح قد يؤدي إلى انخفاض جودة العلاقة.
- التوقعات غير الواقعية: قد يؤدي وضع توقعات غير واقعية على الشريك أو العلاقة بشكل عام إلى تولد الصراعات والخلافات.
- التوتر والضغوط النفسية: قد يؤدي التوتر النفسي والضغوط اليومية المتراكمة إلى زيادة حدة المشاكل الزوجية بدون سبب ملموس. قد يكون لضغوط العمل أو المشاكل الشخصية تأثير كبير على الحياة الزوجية.
- نقص التفهم والتقدير: عدم التفهم المتبادل وعدم الشعور بالتقدير قد يؤدي إلى تفاقم المشاكل في العلاقة الزوجية.
- الصحة النفسية: قد يكون لصحة نفسية سيئة لأحد الزوجين تأثير كبير على العلاقة، حيث قد يتسبب ذلك في تغير المزاج والسلوك.
هذه بعض العوامل النفسية التي يمكن أن تؤدي إلى كثرة المشاكل الزوجية بدون سبب. من المهم أن يعمل الزوجان على التعرف على هذه العوامل ومعالجتها بشكل مناسب لتحسين جودة العلاقة.
الاتصال والتواصل
عندما نتحدث عن المشاكل الزوجية التي تحدث بدون سبب واضح، فإن الاتصال والتواصل الجيد بين الشريكين يلعب دورًا حاسمًا في تجنب هذه المشاكل.
أهمية الاتصال والتواصل الجيد في تجنب المشاكل الزوجية بدون سبب
فهم الاحتياجات والرغبات: عندما يكون هناك اتصال جيد بين الشريكين، يتمكن كل منهما من فهم احتياجات ورغبات الآخر. من خلال الاتصال المفتوح والصادق، يمكن للشركاء أن يعبروا عن ما يشعرون به وما يحتاجون إليه، مما يقلل من احتمالية حدوث المشاكل غير المبررة.
بناء الثقة: الاتصال المستمر والفعّال يساعد على بناء الثقة بين الشريكين. عندما يعرف الشريكان أنهما يمكنهما التحدث بصراحة وبثقة، فإنهما يصبحان أكثر راحة في طرح المشكلات الصغيرة قبل أن تتسع وتتحول إلى مشاكل أكبر.
حل المشكلات بشكل بنّاء: عبر الاتصال والتواصل الجيد، يتم تعزيز القدرة على حل المشاكل بشكل بناء وفعّال. عند توجيه الاهتمام لمعالجة المشاكل قبل أن تتفاقم، يصبح من الأسهل للشريكين التعاون في إيجاد حلول مبتكرة تعزز العلاقة.
التواصل غير اللفظي: ليس التواصل فقط عبارة عن الكلام، بل يتضمن أيضًا التواصل غير اللفظي مثل لغة الجسد والابتسامات والملاحظات غير المباشرة. عند استخدام هذه وسائل التواصل، يمكن للشريكين توضيح مشاعرهم وإظهار حبهم بطريقة غير مباشرة.
لتجنب المشاكل الزوجية بدون سبب، من الأهمية بمكان أن يعمل الشريكان معًا على بناء الاتصال والتواصل الجيد. بينما يمكن أن تكون المشاكل الزوجية لا تحمل سببًا واضحًا في بعض الأحيان، فإن وجود قناة اتصال قوية يسهل على الشريكين معالجة أي تحدي قد يظهر في العلاقة.
التوافق الشخصي
يُعد التوافق الشخصي أحد العوامل الأساسية التي تؤثر على استقرار العلاقات الزوجية. إن كثرة المشاكل الزوجية بدون سبب قد يكون له علاقة وثيقة بعدم وجود توافق شخصي بين الزوجين. يعني ذلك أنه قد يكون هناك اختلافات كبيرة في القيم والاهتمامات بينهما، وقد يؤدي ذلك إلى تعارض وتباعد في آراءهما ومشاعرهما.
أهمية التوافق الشخصي للحفاظ على استقرار العلاقة الزوجية
توفير التوافق الشخصي مع الشريك في حياتك هو جزء أساسي للحفاظ على استقرار علاقتك الزوجية. هنا بعض الأسباب المهمة لأهمية التوافق الشخصي:
- تعزيز التفاهم: عندما يتشابه التفكير والآراء بين الزوجين، يصبح من الأسهل بالنسبة لهما التفاهم والتواصل فيما بينهما. إن ثقافة التفاهم المتبادل تعزز الحب والود بين الزوجين وتجعل العلاقة أكثر استقرارًا.
- تقليل الصراعات: عندما يتوافق الزوجان على معظم المسائل الحياتية المهمة، يصبح من الأسهل تجنب الخلافات والصراعات غير الضرورية. هذا يساعد على خلق بيئة أكثر سعادة وسلام في العلاقة الزوجية.
- تشجيع النمو المشترك: عندما يشارك الزوجان نفس القيم والأهداف في الحياة، فإنهم يستطيعون دفع بعضهما للأمام وتحقيق نمو جماعي. إن قدرة كلا الشريكين على دعم بعضهما في تحقيق أحلامهما الشخصية تعزز رغبة كل منهما في البقاء معًا وتعزيز رابطتهما.
قد يكون التوافق الشخصي مفتاحًا هامًا للحفاظ على سعادة واستقرار العلاقة الزوجية. لذا، قد يكون من المفيد أن تعمل على تعزيز التوافق بينك وبين شريك حياتك لتجنب تكديس المشاكل والصراعات الغير ضرورية.
التحديات الحياتية
في حياتنا اليومية، نواجه العديد من التحديات والصعاب التي قد تؤثر على علاقتنا الزوجية بطرق مختلفة. قد تشمل هذه التحديات:
- ضغوط العمل والمسؤوليات الشخصية
- المشاكل المالية والديون
- صعوبات في التواصل وعدم فهم الاحتياجات والرغبات المتبادلة
- تغيرات في الحياة العائلية مثل ولادة طفل أو خروج الأطفال من المنزل
تأثير التحديات الحياتية على العلاقة الزوجية وكيفية مواجهتها
تؤثر التحديات الحياتية على العلاقة الزوجية بشكل كبير، لكن هناك خطوات يمكن اتخاذها للتغلب على تلك التأثيرات السلبية وتعزيز العلاقة:
- التواصل المفتوح: حافظ على تبادل الأفكار والمشاعر بصدق وصراحة مع شريك حياتك. استخدم الحوار البناء لحل المشاكل وتقديم الدعم المتبادل.
- توزيع المسؤوليات: يساعد تقاسم المسؤوليات المنزلية والمالية على خفض الضغوط وتعزيز الشعور بالتعاون والعدالة.
- صنع وقت للرومانسية: قد يكون من الصعب تخصيص وقت لأنشطة ممتعة ورومانسية في ظل انشغالنا اليومي، لكن استثمار الوقت في القرب والاهتمام ببعضهما البعض يعزز الارتباط والسعادة.
- طلب المساعدة: إذا كانت التحديات تؤثر بشكل كبير على حياتكما، فلا تتردد في طلب المساعدة من خبراء في العلاقات أو من الأصدقاء والأقارب.
تذكر أن التحديات الحياتية طبيعية وجزء لا يتجزأ من حياة الزوجين. باستخدام الاتصال المفتوح والتعاون، يمكنك تقوية علاقتك الزوجية والتغلب على أي مشاكل تواجهها.
المساعدة الاحترافية
بدون سبب ظاهر واضح، تعاني بعض الأزواج من كثرة المشاكل الزوجية. قد يكون السبب في ذلك هو العديد من الأمور، مثل عدم التواصل الجيد، اختلاف التوقعات، صعوبة التكيف مع تغيرات الحياة، أو غيرها من العوامل. وفي بعض الأحيان يكون من الصعب على الأزواج حل تلك المشاكل بمفردهم.
أهمية البحث عن المساعدة الاحترافية في حل المشاكل الزوجية بدون سبب
في حالة استمرار المشاكل بدون سبب وظهور تأثير سلبي على علاقة الزوجين، قد يكون من الضروري البحث عن المساعدة الاحترافية لحل هذه المشكلة. وإليكم بعض أسباب أهمية ذلك:
- الخبرة والمهارات: المساعدة الاحترافية توفر للأزواج الخبرة والمهارات اللازمة لفهم المشكلة وتحديدها بشكل صحيح، بالإضافة إلى توجيههم لاستراتيجيات حل المشاكل بشكل فعال.
- المنظور الخارجي: يوفر الخبراء الاحترافيون منظورًا خارجيًا غير جانبي عن العلاقة، مما يساعد في تفادي الانحياز وتقديم نصائح غير متحيزة.
- تحسين التواصل: قد يكون التواصل ضعيفًا في علاقة الزوجين، وقد يؤدي ذلك إلى زيادة المشكلات وتفاقمها. يساعد الخبراء في تعزيز التواصل الفعال بين الأزواج وتقديم أدوات وتقنيات للتفاهم والتواصل بشكل أفضل.
- إصلاح العلاقة: من خلال تقديم استشارات متخصصة وتوجيهات بناءة، يمكن للمساعدة الاحترافية أن تساعد الأزواج في تطوير علاقتهم وبناء أسس أكثر قوة واستقرارًا.
في النهاية، يُشدد على أهمية البحث عن المساعدة الاحترافية لحل المشاكل الزوجية بدون سبب، حيث يمكن أن تكون فعالة في إحداث تحسينات هامة في علاقة الزوجين وتعزيز سعادتهم ورفاهيتهم.
الثقة والاحترام
أهمية بناء الثقة والاحترام المتبادل في تجنب المشاكل الزوجية بدون سبب
تعاني العديد من الأزواج من المشاكل الزوجية التي تظهر بدون سبب واضح. قد يكون السبب وجود نقص في الثقة والاحترام. إذ أن الثقة والاحترام هما أساس أي علاقة ناجحة، بما في ذلك العلاقات الزوجية.
هناك أهمية كبيرة لبناء الثقة والاحترام المتبادل في تجنب المشاكل الزوجية بدون سبب:
- المشاعر الأمنية: عندما يشعر الشريكان بالثقة والاحترام المتبادل، فإنهم يشعرون بالأمان في علاقتهم. لذلك، فإن بناء هذه المشاعر يقلل من حدوث المشاكل بدون سبب ويخفف من التوتر والخوف.
- التواصل الفعال: عندما يكون هناك ثقة واحترام، يكون التواصل بين الشريكين أكثر فعالية. الثقة تمكن الشريكين من التحدث بصراحة وبثقة في مشاعرهم واحتياجاتهم.
- المرونة: عندما يتمتع الأزواج بثقة واحترام، يصبح من الأسهل عليهم تجاوز الخلافات والتعامل مع المشكلات قبل أن تتطور إلى مشاكل كبيرة. فالأشخاص الذين يثقون في بعضهم البعض يكون لديهم قدرة أفضل على التفاهم والتقبل.
- قوة العلاقة: بناء الثقة والاحترام المتبادل يسهم في تعزيز قوة العلاقة الزوجية. عندما تكون هناك ثقة واحترام، يصبح من الممكن للأزواج أن يستمروا في دعم بعضهم البعض في جميع المراحل التي يمر بها الحياة.
في النهاية: بناء الثقة والاحترام المتبادل في علاقة الزوجية هو مفتاح لتجنب المشاكل بدون سبب. عندما يشعر الشريكان بالأمان والتقدير، تتقلص فرص حدوث المشاكل غير المبررة وتزداد قوة العلاقة.
الحفاظ على التوازن
قد يعاني الكثيرون من مشاكل في الحياة الزوجية بدون سبب واضح. واحدة من الأسباب المحتملة لذلك هي عدم الحفاظ على التوازن بين الحياة العملية والحياة الزوجية.
أهمية الحفاظ على التوازن بين الحياة العملية والحياة الزوجية
تعتبر حياة الزوجية والعملية جزءًا أساسيًا من حياتنا، ولكن من المهم أن نجد التوازن بينهما للحفاظ على استقرار حياتنا.
إليك بعض أهمية الحفاظ على التوازن بين الحياة العملية والحياة الزوجية:
- الصحة والسعادة: عندما نجد التوازن المثالي بين عملنا وحياتنا الزوجية، نكون أكثر سعادة ورضاء. كما يؤثر ذلك بشكل إيجابي على صحتنا العامة ويرفع مستوى الرضا في حياتنا.
- جودة العلاقة الزوجية: إذا لم يتم الاهتمام بالحياة الزوجية بتوازن مع الحياة العملية، فقد يؤدي ذلك إلى انخفاض جودة العلاقة مع الشريك. من المهم أن نقدم الوقت والجهد لبناء وتقوية الروابط العاطفية والتواصل المفتوح في الحياة الزوجية.
- الأداء المهني: عندما نستطيع تحقيق توازن جيد بين العمل والزواج، ينعكس ذلك على أداءنا المهني. نصبح أكثر تركيزًا وإبداعًا، مما يؤدي إلى تحسين فرصنا المهنية ونجاحنا في مجالات عملنا.
- السلام الداخلي: عندما نجد التوازن بين حياتنا العملية والحياة الزوجية، نشعر بالسلام الداخلي والانسجام. يساعد ذلك على تقليل التوتر وزيادة الرضا عن الذات.
بفضل الحفاظ على التوازن بين الحياة العملية والحياة الزوجية، يمكن تجنب العديد من المشاكل الزوجية غير المبررة وتحقيق حياة سعيدة ومتوازنة في نفس الوقت.
الخاتمة
في النهاية، يُعتبر التوجه إلى العلاقة الزوجية المثلى وتفادي كثرة المشاكل بدون سبب أمرًا هامًا للغاية. ولكن هناك بعض النصائح الأساسية التي يجب أن تتبعها لضمان الحفاظ على علاقتك الزوجية:
نصائح نهائية لتجنب كثرة المشاكل الزوجية بدون سبب والحفاظ على العلاقة الزوجية
- الاتصال المستمر: قم بالتواصل المستمر مع شريك حياتك وعبر عن مشاعرك وأفكارك. كونا فريقًا وتعاملا معًا في جميع جوانب الحياة.
- التفهم المتبادل: حاول أن تكون مفهومًا لشريكك وتتفهم احتياجاته ورغباته. تذكر أن كل شخص فرد فريد بخصوصية داخل العلاقة الزوجية.
- المرونة: كن مستعدًا لتبني المرونة في العلاقة وتحسين الاتفاقيات. لا تحاول أن تفرض وجهة نظرك بشكل قاسي، بل قدر آراء شريكك.
- التعلم المستمر: استمر في تطوير مهاراتك كزوج وتواصل مع شريكك بشكلٍ إيجابي. اقرأ الكتب واتبع الدورات التدريبية التي تركز على تطوير علاقات الزوجية.
- تجاهل الصغائر: لا تأخذ الأمور الصغيرة بجدية كبيرة. حافظ على مرونة نظرتك وتفهم لاخطاء شريكك.
- الاحتفاظ بالرومانسية: لا تنسَ أهمية الرومانسية داخل العلاقة الزوجية. قم بإبقاء شرارة حبك مشتعلة من خلال المفاجآت والهدايا الصغيرة.
- طلب المشورة: في حالة عدم قدرتك على حل المشكلات بمفردك، لا تتردد في طلب المشورة من خبراء زواج أو مستشاري علاقات الأزواج.
باتباع هذه النصائح، يُمكن أن تقلل من كثرة المشاكل الزوجية بدون سبب وأن تحفظ علاقتك الزوجية قوية وسليمة.
اقرأ أيضًا: